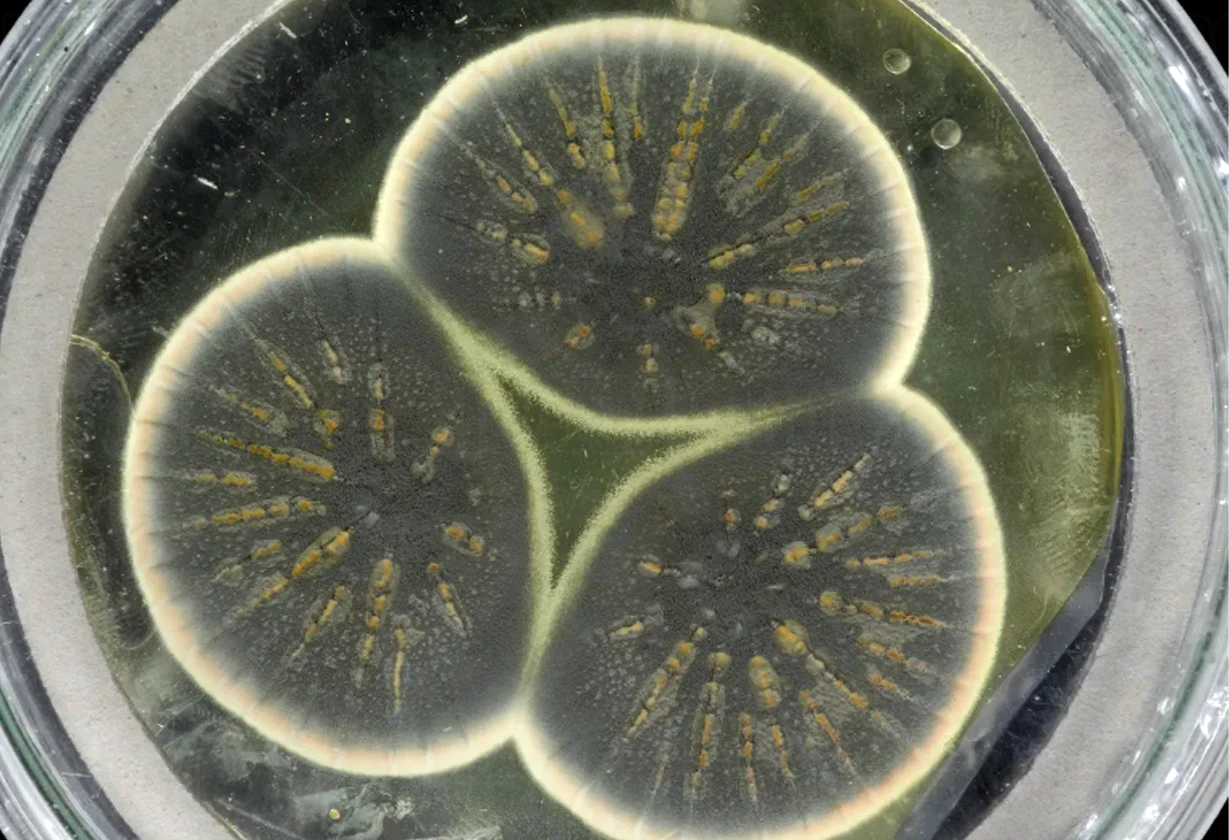

La IA médica muestra avances, pero aún presenta errores y riesgos que exigen supervisión profesional en el uso cotidiano por usuarios

La IA médica muestra avances, pero aún presenta errores y riesgos que exigen supervisión profesional en el uso cotidiano por usuarios

La carrera de Medicina de la UNLPam muestra mayoría femenina y desarrolla un modelo educativo centrado en simulación clínica y prevención.

Formación médica en La Pampa con prácticas en hospitales y telemedicina para fortalecer la red sanitaria provincial.

Centro de Simulación de la UNLPam fortalece la formación médica con tecnología avanzada y prácticas seguras.

Marianela Fernández, de 76 años, inició Medicina en la UNLPam. Su historia, la formación enfocada en personas y el impacto en La Pampa.

Comenzó Medicina en la UNLPam con 738 estudiantes, mayoría pampeana. Formación, telemedicina y plan integrado fortalecen la salud provincial

La UNLPam inició Medicina con 740 alumnos, enfoque territorial y respaldo provincial, apostando a formar médicos comprometidos con la comunidad.

El Premio Nobel de Fisiología o Medicina 2025 fue concedido a Mary E. Brunkow, Fred Ramsdell y Shimon Sakaguchi

En el panorama actual de la medicina, persiste un legado del pasado que merece nuestra atención crítica: las ampollas de vidrio
Desde el descubrimiento de la penicilina hace casi un siglo, la medicina ha buscado constantemente nuevos antibióticos para enfrentar las crecientes amenazas de resistencia microbiana